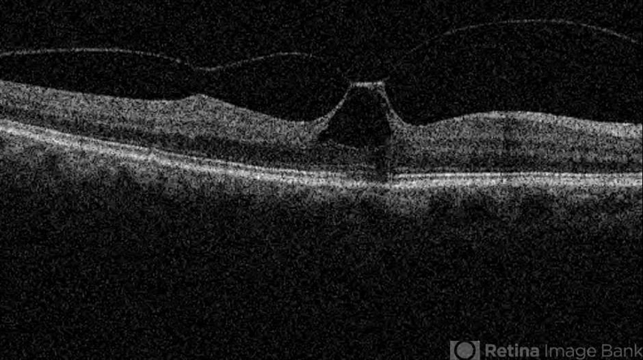
file

-
---thumb.jpg/image-square;max$48,0.ImageHandler) By Hamid Ahmadieh, MD
By Hamid Ahmadieh, MD
Labbafinejad Medical Center - Uploaded on Sep 24, 2013.
- Last modified by Caroline Bozell on Sep 24, 2013.
- Rating
- Appears in
- Miscellaneous
- Condition/keywords
- vitreomacular traction (VMT), optical coherence tomography (OCT)
- Photographer
- Soodabeh Fooladin, Negah Eye Center, Tehran, Iran
- Imaging device
- Topcon OCT
- Description
- OCT image of the right eye of a 70-year-old woman with visual disturbance due to VMT.

Initializing download.
Initializing download.










